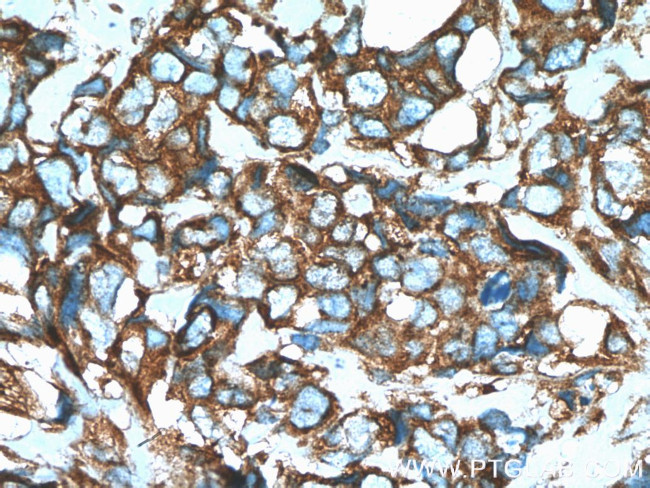
GEF-H1 Antibody in Immunohistochemistry (Paraffin) (IHC (P))
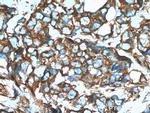
GEF-H1 Antibody in Immunohistochemistry (Paraffin) (IHC (P))

Search
Proteintech
GEF-H1 Polyclonal Antibody
{{$productOrderCtrl.translations['antibody.pdp.commerceCard.promotion.promotions']}}
{{$productOrderCtrl.translations['antibody.pdp.commerceCard.promotion.viewpromo']}}
{{$productOrderCtrl.translations['antibody.pdp.commerceCard.promotion.promocode']}}: {{promo.promoCode}} {{promo.promoTitle}} {{promo.promoDescription}}. {{$productOrderCtrl.translations['antibody.pdp.commerceCard.promotion.learnmore']}}
产品信息
24472-1-AP
种属反应
宿主/亚型
分类
类型
抗原
偶联物
形式
浓度
规格
纯化类型
保存液
内含物
保存条件
运输条件
产品详细信息
Immunogen sequence: PRGLFRSES LESPRGERLL QDAIREVEGL KDLLVGPGVE LLLTPREPAL PLEPDSGGNT SPGVTANGEA RTFNGSIELC RADSDSSQRD RNGNQLRSPQ EEALQRLVNL YGLLHGLQAA VAQQDTLMEA RFPEGPERRE KLCRANSRDG EAGRAGAAPV APEKQATELA LLQRQHALLQ EELRRCRRLG EERATEAGSL EARLRESEQA RALLEREAEE ARRQLAALGQ TEPLPAEAPW ARRPVDPRRR SLPAGDALYL SFNPPQPSRG TDRLDLPVTT RSVHRNFEDR ERQELGSPEE RLQDSSDPDT GSEEEGSSRL SPPHSPRDFT RMQDIPEETE SRDGEAVASE S (610-959 aa encoded by BC020567)
靶标信息
GEF-H1 activates Rho GTPases by promoting the exchange of GDP and GTP. Rho GTPases play a fundamental role in numerous cellular processes that are initiated by extracellular stimuli that work through G protein coupled receptors. GEF-H1 may be involved in epithelial barrier permeability, cell motility and polarization, dendritic spine morphology, antigen presentation, leukemic cell differentiation, cell cycle regulation, innate immune response, and cancer. Alternatively spliced transcript variants encoding different isoforms have been identified.
仅用于科研。不用于诊断过程。未经明确授权不得转售。
生物信息学
蛋白别名: DKFZp547L106; DKFZp547P1516; FLJ45440; GEF-H1; Guanine nucleotide exchange factor H1; Microtubule-regulated Rho-GEF; OTTHUMP00000018855; Proliferating cell nucleolar antigen p40; Rho guanine nucleotide exchange factor 2; Rho/Rac guanine nucleotide exchange factor (GEF) 2; unnamed protein product
基因别名: ARHGEF2; GEF; GEF-H1; GEFH1; KIAA0651; Lfc; LFP40; NEDMHM; P40
UniProt ID: (Human) Q92974
Entrez Gene ID: (Human) 9181